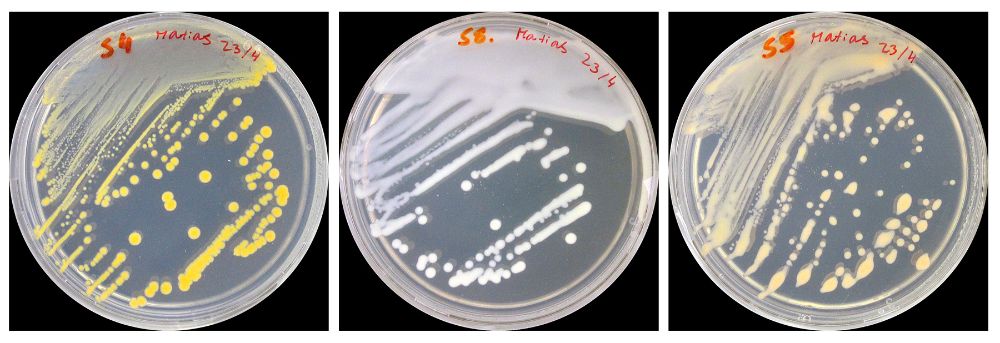
Ascotán

El Salar de Ascotán es uno de los 52 salares del desierto de Atacama, un lugar rico en metales pesados como el arsénico, el cadmio y el cobre, que además está expuesto a elevados niveles de radiación ultravioleta y salinidad, así como a condiciones extremas de altitud, oscilación térmica y bajos niveles de oxígeno. Esta inhóspita zona, ubicada en el norte de la Región de Antofagasta, a 3.716 metros de altura, y muy cerca de la frontera con Bolivia, fue explorada por investigadores de la Facultad de Ciencias de la Universidad de Chile con el propósito de conocer las formas de vida capaces de sobrevivir en este tipo de entornos tremendamente hostiles, de los cuales aún se sabe poco.
La investigación, que analizó muestras de agua, suelo y sedimento, no solo permitió conocer los mecanismos que hacen posible la vida en estas condiciones, también significó el descubrimiento de microorganismos de los que no se tenía registro, hallazgos que fueron dados a conocer en la revista científica Microorganisms. A partir de la reconstrucción de genomas, el estudio identificó dos nuevas familias de bacterias, de los grupos Patescibacteria y Pseudomonadota, así como dos nuevos órdenes de las clases de arqueas Halobacteriota y Thermoplasmata. El trabajo, además, reveló parte de la biodiversidad microbiana de este entorno, donde predominan bacterias, principalmente de los grupos Pseudomonadota, Acidobacteriota y Bacteroidota.
Una ventana al origen de la vida
Andrés Marcoleta, académico que encabezó esta investigación, explica que toda la vida en nuestro planeta hoy está dividida en tres grandes dominios taxonómicos: bacterias, arqueas y eucariotas. En este último dominio es donde nos encontramos nosotros, los seres humanos, así como animales, plantas y hongos, organismos caracterizados por sus células con un núcleo bien definido. “Las arqueas están presentes desde los inicios de la vida en nuestro planeta y los eucariotas se supone que evolucionamos a partir de alguna arquea. De hecho, estudios muy recientes indican que nuestro ancestro más cercano es una arquea, que en algún momento se fusionó con una bacteria, y eso dio origen a una célula eucariota, y de ahí en adelante la evolución siguió su camino”, explica.
El microbiólogo de la Universidad de Chile afirma que las arqueas son de gran importancia científica, ya que son por lejos el dominio menos estudiado y menos conocido de la vida en nuestro planeta. “La verdad es que cuesta encontrarlas y muchas de ellas son extremófilas, por lo que tienen mecanismos de adaptación que les permiten sobrevivir en ambientes con condiciones extremas, como los salares”, sostiene el profesor Marcoleta, quien detalla que estos microorganismos fueron encontrados principalmente en las muestras de suelo del entorno del salar. Mediante herramientas de informática, agrega, pudieron reconstruir el genoma de estas primitivas formas de vida y, de esta manera, conocer sus metabolismos.
Por otra parte, destaca que consiguieron identificar numerosos linajes de bacterias, incluidas dos nuevas familias, e incluso pudieron cultivar algunas en laboratorio. Al igual que con las arqueas, el equipo pudo comprender las características y funciones de estos microorganismos a partir de la reconstrucción de su genoma. Respecto a los principales hallazgos asociados a estas bacterias, el profesor Marcoleta afirma que, sobre todo aquellas que habitan en el medio acuático, “tienen una alta proporción de genes de resistencia y de reparación de ADN. Esa podría ser una de las explicaciones de por qué pueden tolerar niveles tan altos de radiación ultravioleta”, que provoca quiebres o modificaciones del ADN y, finalmente, terminan siendo tóxicas para las células.
Orestias ascotanensis: un milagro evolutivo
Las capacidades adaptativas para sobrevivir en este inhóspito lugar también fueron observadas en un organismo endémico del Salar de Ascotán mucho más complejo: el enigmático Orestias ascotanensis, pez único en el mundo que fue objeto de estudio en otra investigación encabezada por Miguel Allende, también profesor de la Facultad de Ciencias de la Universidad de Chile y director del Centro de Regulación del Genoma (CRG). El equipo liderado por el académico secuenció el genoma de este pequeño pez para descifrar su historia evolutiva y comprender cómo se adaptó para prosperar en este hábitat extremo, tan distinto al ambiente original que tenía el pez antecesor de ellos en un pasado remoto, un trabajo publicado en la revista científica Genomics.
El profesor Allende explica que el interés en este ser vivo nace precisamente por las circunstancias geológicas a través de las cuales quedó “aislado” para volverse una especie única. Según explica, producto del choque de placas tectónicas, se levantó la cordillera de los Andes y los grandes lagos que existían al interior del continente se fragmentaron, algunos de los cuales son los salares que hoy existen en el altiplano. “Los salares se secaron en su mayoría, pero algunos conservaron pequeñas vertientes y ahí todavía viven estos peces. Desde hace decenas de miles de años que se separaron unos de otros y se han ido especiando, adaptándose a las condiciones particulares de cada lago o cada salar”, señala el académico.
Orestias ascotanensis, en este sentido, representa un buen modelo para entender cómo una especie puede cambiar en términos genéticos para adaptarse a ciertas condiciones ambientales, en línea con la selección natural y la deriva genética propuesta por Darwin, paradigma donde se plantea que aquellos organismos capaces de sobrevivir a los cambios del entorno son los que prosperan. “Los Orestes tienen que haber experimentado lo mismo cuando pasaron de agua dulce a agua salada, y a poco oxígeno y mucha radiación. Aquellos individuos que pudieron sobrevivir en esas condiciones predominaron y generaron un cambio en la especie. Hoy podemos comparar la información del genoma de estos peces con la de aquellos que no sufrieron tantos cambios para ver qué cosas se modificaron y, por lo tanto, qué genes se necesitan para tolerar esas condiciones”, detalla Miguel Allende.
Aplicaciones biotecnológicas: desde la biominería a la agricultura resiliente
Los académicos a cargo de estas investigaciones en el Salar de Ascotán plantean, por otra parte, que las capacidades extraordinarias de supervivencia de estos organismos ofrecen diversas posibilidades para explorar potenciales aplicaciones biotecnológicas a partir de sus genes, como la respuesta al estrés, la reparación del ADN, la resistencia a metales pesados como el arsénico, el cadmio y el cobre, y la tolerancia a condiciones extremas de salinidad, radiación ultravioleta, gran altitud y oscilación térmica, entre otros aspectos.
Estos genes de resistencia pueden ser aplicados a distintos procesos industriales, como la biominería. “Junto con colegas de la Universidad Católica del Norte, ahora estamos postulando a un proyecto de salares y litio que justamente pretende aprovechar microorganismos de salares para hacer minería de litio a partir de chatarra electrónica. Uno puede ocupar ciertas cepas que están en los salares, y que tienen alta tolerancia a metales, de modo que tienen la capacidad de obtener el metal o compuesto y acumularlo. Propiedades como esas se pueden aprovechar para hacer minería de litio a partir de desechos y no tener que sacrificar nuestros salares, simplemente utilizar los microorganismos que viven ahí”, señala el profesor Andrés Marcoleta.
Otra aplicación biotecnológica de interés tiene relación con los procesos de desertificación y sequías que viven Chile y otros países en el marco del cambio climático, fenómenos que impactan, por ejemplo, sobre nuestra producción agrícola y forestal. “Entender cómo las especies se adaptan a cambios ambientales es importante para poder después aplicar eso y seleccionar aquellas variedades o individuos que sean capaces de tolerar estas nuevas condiciones del entorno. En esta línea, podemos tener una especie de programa genético para asegurar nuestra seguridad alimentaria futura, que puede estar en peligro”, plantea el profesor Miguel Allende.
“Uno podría pensar en cultivos en el desierto, en suelos que están muy pobres de nutrientes o contaminados con metales pesados. Si uno pone los microorganismos correctos o los modifica genéticamente, de manera que puedan funcionar en esos ambientes, pueden enriquecer esos suelos y hacer que sea posible cultivarlos”, agrega el director del Centro de Regulación del Genoma, quien menciona esta alternativa a propósito de la progresiva disminución de tierras fértiles y útiles adecuadas para la agricultura. “Tenemos que buscar herramientas ahora para aprovechar otros lugares, y eso creo que es una de las contribuciones más importante de los hallazgos que se hacen con estos microorganismos del desierto”, complementa.
Marcoleta también apunta a la posibilidad de desarrollar soluciones de biorremediación a través de la genética de estos extremófilos, por ejemplo, ante contaminación por radioactividad. “Algunos de los linajes bacterianos que encontramos son las bacterias Deinococcus radiodurans, que son famosas por ser una de las bacterias que más resisten la radiación gamma. Resisten perfectamente la radiación gamma de los rayos cósmicos que uno encuentra en el espacio y, por lo tanto, son bacterias capaces de sobrevivir en el espacio exterior. Entonces, si uno quisiera hacer biorremediación de lugares contaminados por radioactividad, podría pensar en aprovechar alguna de estas bacterias y su resistencia a la radiación gamma”.